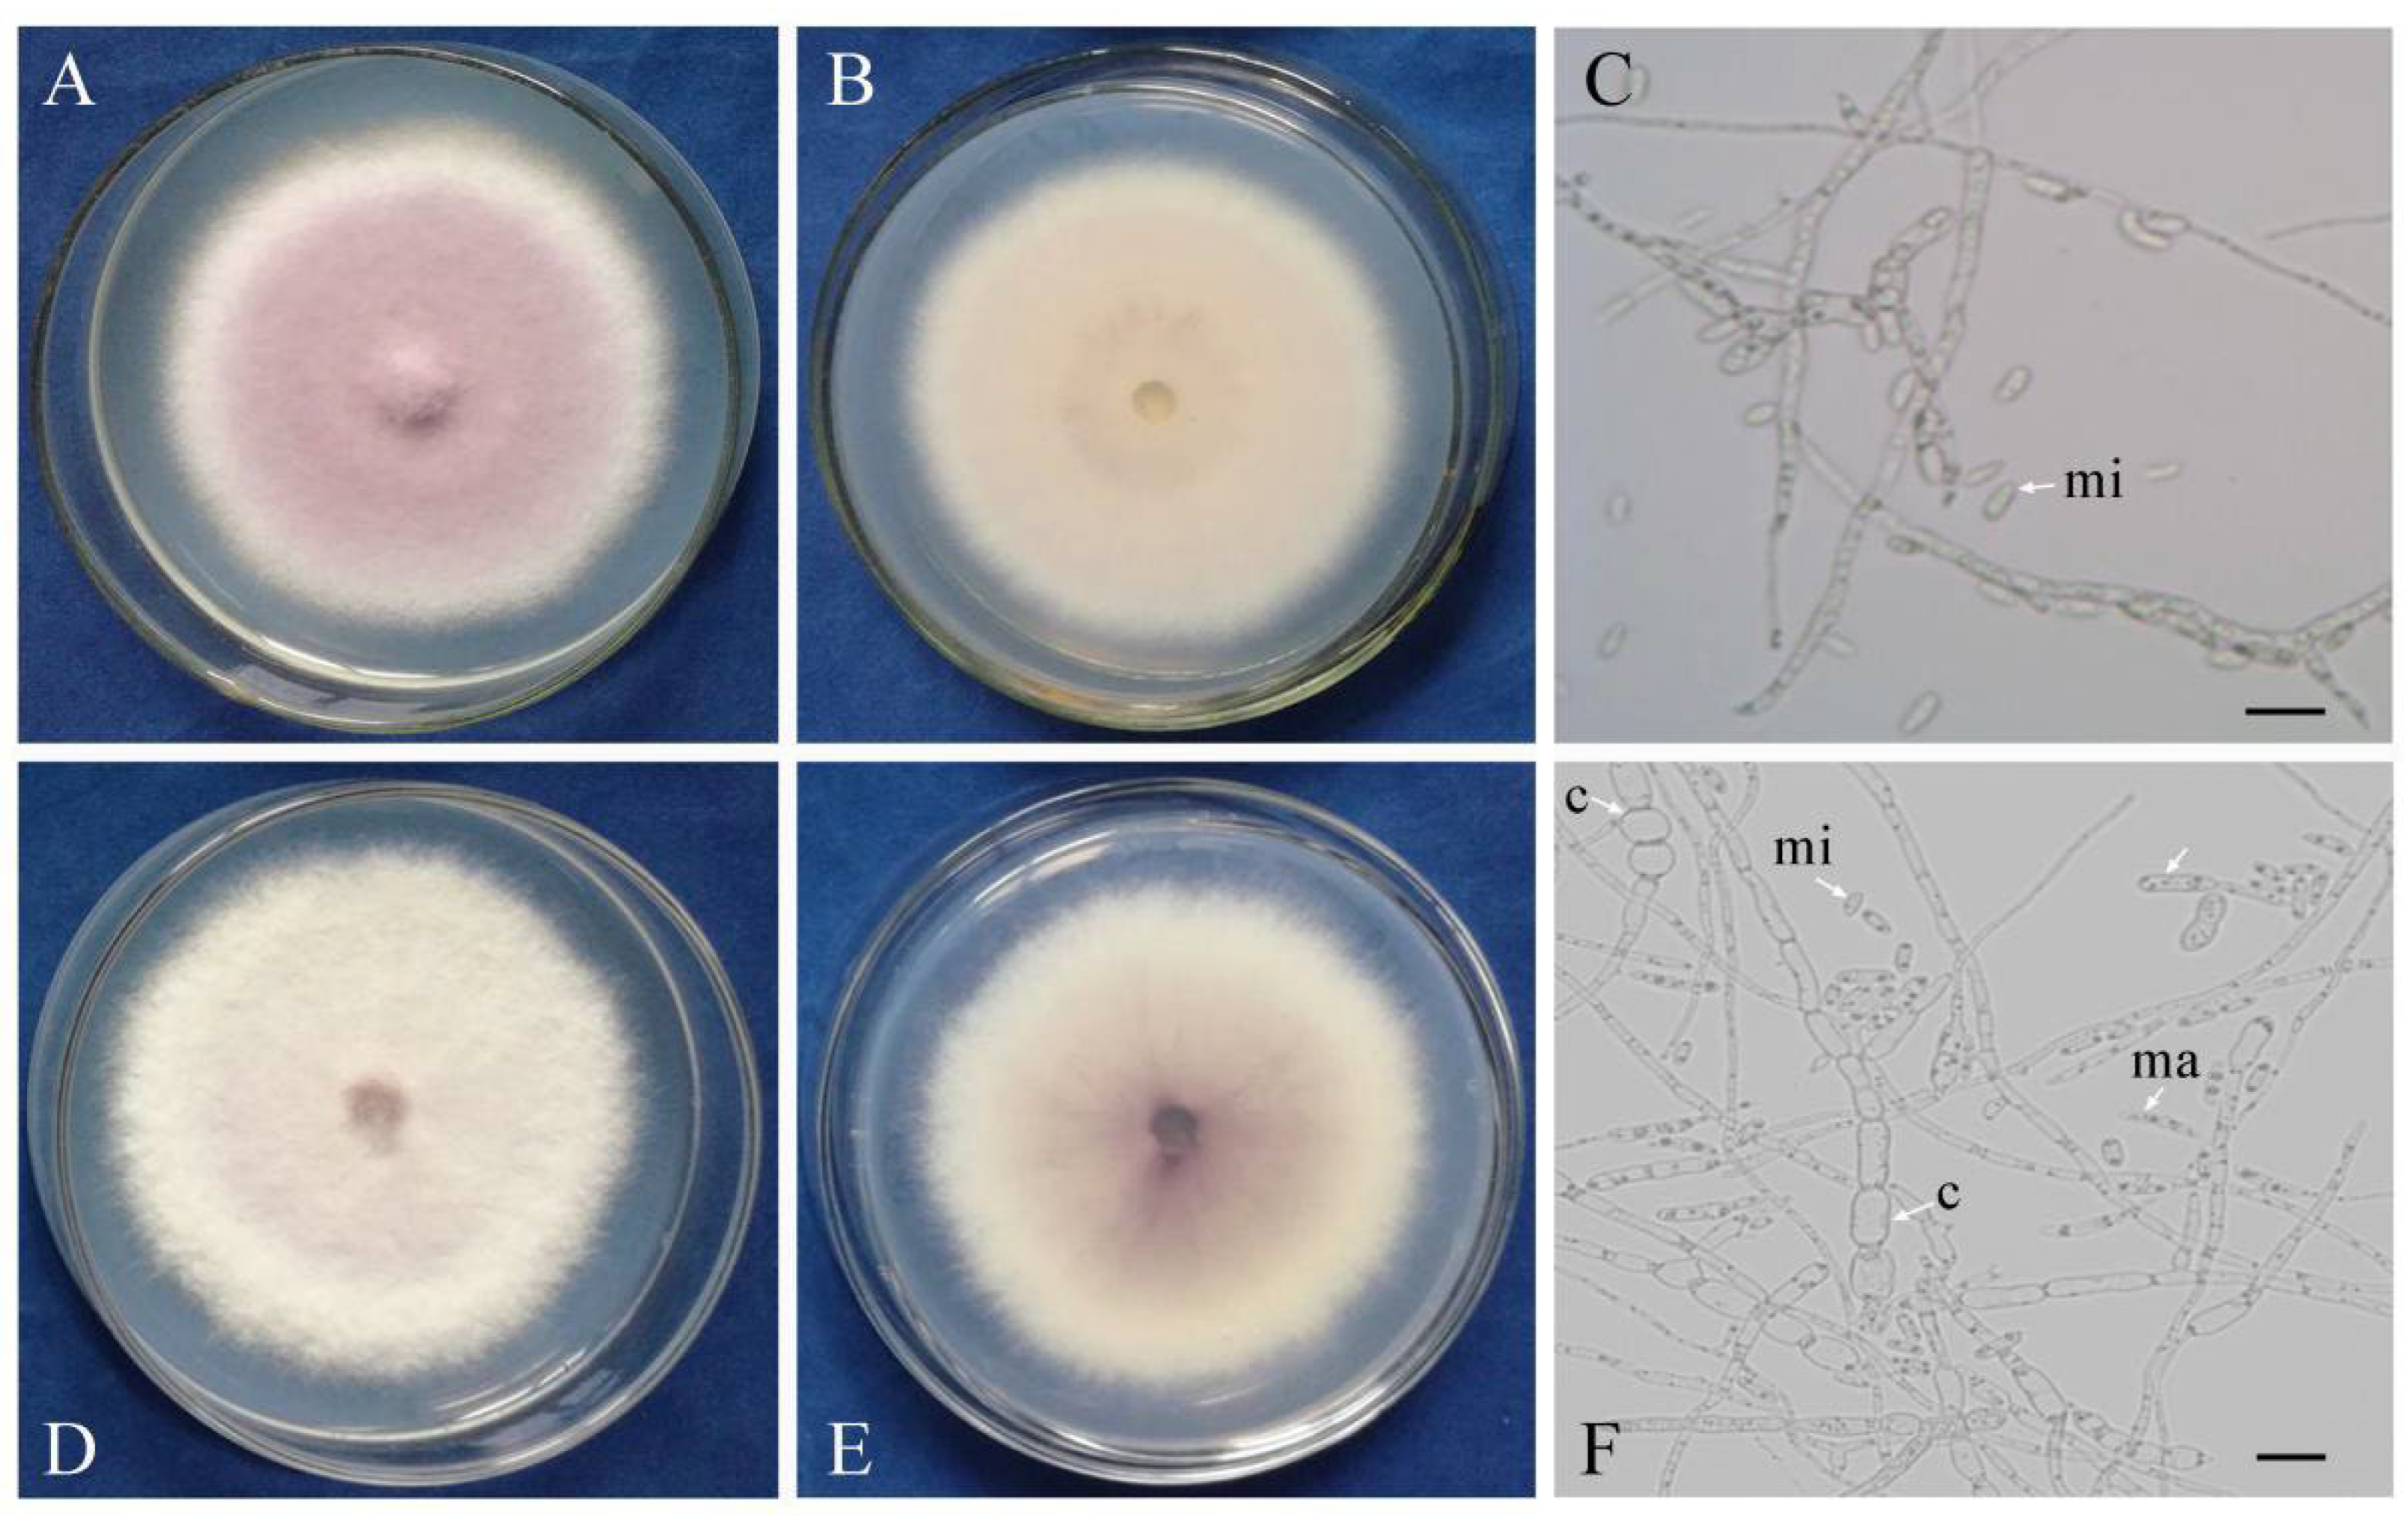

Increased Conidia Production and Germination In Vitro Correlate with Virulence Enhancement in Fusarium oxysporum f. sp. cucumerinum
Abstract
1. Introduction
2. Materials and Methods
2.1. Strains
2.2. Morphological Observation
2.3. Mycelia Growth
2.4. Conidia Production and Germination
2.5. Stress Tolerance
2.6. Virulence
2.7. Colonization in Cucumber
2.8. Statistical Analysis
3. Results
3.1. The InVir Strain Showed Slight Morphological Changes
3.2. Mycelia of the InVir Strain Grew Faster Than the WT Strain
3.3. The InVir Strain Produced More Conidia with a Higher Germination Rate Than the WT Strain
3.4. The InVir Strain Exhibited Variation in Responding to Different Stresses
3.5. The InVir Strain Was More Aggressive in Cucumber Than the WT Strain
3.6. The InVir Strain Colonized in the Cucumber Vascular Faster Than the WT Strain
4. Discussion
Supplementary Materials
Author Contributions
Funding
Institutional Review Board Statement
Informed Consent Statement
Data Availability Statement
Conflicts of Interest
References
- Gordon, T.R.; Martyn, R.D. The evolutionary biology of Fusarium oxysporum. Annu. Rev. Phytopathol. 1997, 35, 111–128. [Google Scholar] [CrossRef] [PubMed]
- Gordon, T.R. Fusarium oxysporum and the Fusarium wilt syndrome. Annu. Rev. Phytopathol. 2017, 55, 23–39. [Google Scholar] [CrossRef]
- Edel-Hermann, V.; Lecomte, C. Current status of Fusarium oxysporum formae speciales and races. Phytopathology 2019, 109, 512–530. [Google Scholar] [CrossRef] [PubMed]
- Zhou, X.; Wu, F. Dynamics of the diversity of fungal and Fusarium communities during continuous cropping of cucumber in the greenhouse. FEMS Microbiol. Ecol. 2012, 80, 469–478. [Google Scholar] [CrossRef] [PubMed]
- Pu, Z.; Zhang, Y.; Liu, D.; Dai, L.; Wang, W. Research progress in biological control strategies for Fusarium wilt of cucumber. China Veg. 2011, 6, 9–14. [Google Scholar]
- Shen, C.; Xiong, L.; Han, S.; Ma, J.; Wu, J. The production and circulation of fruit vegetables in China. China Veg. 2017, 1, 7–11. [Google Scholar]
- Shen, W.; Lin, X.; Gao, N.; Zhang, H.; Yin, R.; Shi, W.; Duan, Z. Land use intensification affects soil microbial populations, functional diversity and related suppressiveness of cucumber Fusarium wilt in China’s Yangtze River Delta. Plant Soil 2008, 306, 117–127. [Google Scholar] [CrossRef]
- Stajich, J.E.; Berbee, M.L.; Blackwell, M.; Hibbett, D.S.; James, T.Y.; Spatafora, J.W.; Taylor, J.W. The Fungi. Curr. Biol. 2009, 19, R840–R845. [Google Scholar] [CrossRef]
- Barriuso, J.; Hogan, D.A.; Keshavarz, T.; Jesus Martinez, M. Role of quorum sensing and chemical communication in fungal biotechnology and pathogenesis. FEMS Microbiol. Rev. 2018, 42, 627–638. [Google Scholar] [CrossRef]
- Petriacq, P.; Stassen, J.H.M.; Ton, J. Spore density determines infection strategy by the plant pathogenic fungus Plectosphaerella cucumerina. Plant Physiol. 2016, 170, 2325–2339. [Google Scholar] [CrossRef]
- Michielse, C.B.; Rep, M. Pathogen profile update: Fusarium oxysporum. Mol. Plant Pathol. 2009, 10, 311–324. [Google Scholar] [CrossRef]
- Huang, X.; Sun, M.; Lu, X.; Li, S. Serial passage through resistant and susceptible cucumber cultivars affects the virulence of Fusarium oxysporum f. sp. cucumerinum. MicrobiologyOpen 2019, 8, e641. [Google Scholar]
- Zhang, L.; Li, S.; Miao, Z. Pathogenicity variation and genetic structure differentiation of Fusarium oxysporum f. sp. conglutinans in soil under successive cultivation of Brassica oleracea. ACTA Phytopathol. Sin. 2013, 43, 58–68. [Google Scholar]
- Jiménez-Gasco, M.M.; Navas-Cortés, J.A.; Jiménez-Díaz, R.M. The Fusarium oxysporum f. sp. ciceris/Cicer arietinum pathosystem: A case study of the evolution of plant-pathogenic fungi into races and pathotypes. Int. Microbiol. 2004, 7, 95–104. [Google Scholar]
- Wang, B.; Brubaker, C.L.; Tate, W.; Woods, M.J.; Burdon, J.J. Evolution of virulence in Fusarium oxysporum f. sp. vasinfectum using serial passage assays through susceptible cotton. Phytopathology 2008, 98, 296–303. [Google Scholar]
- Harris, J.M.; Balint-Kurti, P.; Bede, J.C.; Day, B.; Gold, S.; Goss, E.M.; Grenville-Briggs, L.J.; Jones, K.M.; Wang, A.; Wang, Y.; et al. What are the top 10 unanswered questions in molecular plant-microbe interactions? Mol. Plant-Microbe Interact. 2020, 33, 1354–1365. [Google Scholar] [CrossRef]
- Sacristán, S.; Goss, E.M.; Eves-van den Akker, S. How do pathogens evolve novel virulence activities? Mol. Plant-Microbe Interact. 2021, 34, 576–586. [Google Scholar] [CrossRef]
- Huang, X.Q.; Lu, X.H.; Sun, M.H.; Guo, R.J.; Van Diepeningen, A.D.; Li, S.D. Transcriptome analysis of virulence-differentiated Fusarium oxysporum f. sp. cucumerinum isolates during cucumber colonisation reveals pathogenicity profiles. BMC Genom. 2019, 20, 570. [Google Scholar]
- Barrett, L.G.; Bell, T.; Dwyer, G.; Bergelson, J. Cheating, trade-offs and the evolution of aggressiveness in a natural pathogen population. Ecol Lett. 2011, 14, 1149–1157. [Google Scholar] [CrossRef]
- Paisely, D.; Robson, G.D.; Denning, D.W. Correlation between in vitro growth rate and in vivo virulence in Aspergillus fumigatus. Medical Mycol. 2005, 43, 397–401. [Google Scholar] [CrossRef] [PubMed]
- Pagán, I.; Alonso-Blanco, C.; García-Arenal, F. Host responses in life-history traits and tolerance to virus infection in Arabidopsis thaliana. PLoS Pathog. 2008, 4, e1000124. [Google Scholar] [CrossRef] [PubMed]
- Vakalounakis, D.J.; Wang, Z.; Fragkiadakis, G.A.; Skaracis, G.N.; Li, D.-B. Characterization of Fusarium oxysporum isolates obtained from cucumber in China by pathogenicity, VCG, and RAPD. Plant Dis. 2004, 88, 645–649. [Google Scholar] [CrossRef] [PubMed][Green Version]
- Bernasconi, A.; Alassimone, J.; McDonald, B.A.; Sanchez-Vallet, A. Asexual reproductive potential trumps virulence as a predictor of competitive ability in mixed infections. Environ. Microbiol. 2022, 24, 4369–4381. [Google Scholar] [CrossRef]
- Ohlberger, J.; Langangen, O.; Edeline, E.; Olsen, E.M.; Winfield, I.J.; Fletcher, J.M.; Ben James, J.; Stenseth, N.C.; Vollestad, L.A. Pathogen-induced rapid evolution in a vertebrate life-history trait. Proc. R. Soc. B-Biol. Sci. 2011, 278, 35–41. [Google Scholar] [CrossRef] [PubMed]
- DeVay, J.E.; Gutierrez, A.P.; Pullman, G.S.; Wakeman, R.J.; Garber, R.H.; Jeffers, D.P.; Smith, S.N.; Goodell, P.B.; Roberts, P.A. Inoculum densities of Fusarium oxysporum f. sp. vasinfectum and Meloidogyne incognita in relation to the development of Fusarium wilt and the phenology of cotton plants (Gossypium hirsutum). Phytopathology 1997, 87, 341–346. [Google Scholar]
- Tooley, P.W.; Browning, M.; Leighty, R.M. Inoculum density relationships for infection of some Eastern US forest species by Phytophthora ramorum. J. Phytopathol. 2013, 161, 595–603. [Google Scholar] [CrossRef]
- Evison, S.E.F.; Foley, K.; Jensen, A.B.; Hughes, W.O.H. Genetic diversity, virulence and fitness evolution in an obligate fungal parasite of bees. J. Evol. Biol. 2015, 28, 179–188. [Google Scholar] [CrossRef]
- Baltussen, T.J.H.; Zoll, J.; Verweij, P.E.; Melchers, W.J.G. Molecular mechanisms of conidial germination in Aspergillus spp. Microbiol. Mol. Biol. Rev. 2020, 84, e00049-19. [Google Scholar] [CrossRef]
- Buxton, E.W. Some effects of pea root exudates on physiologic races of Fusarium oxysporum Fr. f. pisi (Linf.). Trans. Br. Mycol. Soc. 1957, 40, 145–154. [Google Scholar] [CrossRef]
- Bruns, E.; Carson, M.; May, G. Pathogen and host genotype differently affect pathogen fitness through their effects on different life-history stages. BMC Evol. Biol. 2012, 12, 135. [Google Scholar] [CrossRef]
- Li, C.; Chen, S.; Zuo, C.; Sun, Q.; Ye, Q.; Yi, G.; Huang, B. The use of GFP-transformed isolates to study infection of banana with Fusarium oxysporum f. sp. cubense race 4. Eur. J. Plant Pathol. 2011, 131, 327–340. [Google Scholar] [CrossRef]
- Wu, F.; Liu, B.; Zhou, X. Effects of root exudates of watermelon cultivars differing in resistance to Fusarium wilt on the growth and development of Fusarium oxysporum f. sp. niveum. Allelopathy J. 2010, 25, 403–414. [Google Scholar]
- Meyer, S.E.; Stewart, T.E.; Clement, S. The quick and the deadly: Growth vs virulence in a seed bank pathogen. New Phytol. 2010, 187, 209–216. [Google Scholar] [CrossRef] [PubMed]
- Fabre, F.; Bormann, J.; Urbach, S.; Roche, S.; Langin, T.; Bonhomme, L. Unbalanced roles of fungal aggressiveness and host cultivars in the establishment of the Fusarium head blight in bread wheat. Front. Microbiol. 2019, 10, 2857. [Google Scholar] [CrossRef]
- Faino, L.; Seidl, M.F.; Shi-Kunne, X.; Pauper, M.; Van Den Berg, G.C.M.; Wittenberg, A.H.J.; Thomma, B.P.H.J. Transposons passively and actively contribute to evolution of the two-speed genome of a fungal pathogen. Genome Res. 2016, 26, 1091–1100. [Google Scholar] [CrossRef]
- Singh, N.K.; Badet, T.; Abraham, L.; Croll, D. Rapid sequence evolution driven by transposable elements at a virulence locus in a fungal wheat pathogen. BMC Genom. 2021, 22, 393. [Google Scholar] [CrossRef]
- McDonald, M.C.; Taranto, A.P.; Hill, E.; Schwessinger, B.; Liu, Z.; Simpfendorfer, S.; Milgate, A.; Solomon, P.S. Transposon-mediated horizontal transfer of the host-specific virulence protein ToxA between three fungal wheat pathogens. mBio 2019, 10, e01515-19. [Google Scholar] [CrossRef]
- Mundt, C.C. Use of multiline cultivars and cultivar mixtures for disease management. Annu. Rev. Phytopathol. 2002, 40, 381–410. [Google Scholar] [CrossRef]
- Clin, P.; Grognard, F.; Andrivon, D.; Mailleret, L.; Hamelin, F.M. Host mixtures for plant disease control: Benefits from pathogen selection and immune priming. Evol. Appl. 2022, 15, 967–975. [Google Scholar] [CrossRef]
- Mikaberidze, A.; McDonald, B.A.; Bonhoeffer, S. Developing smarter host mixtures to control plant disease. Plant Pathol. 2015, 64, 996–1004. [Google Scholar] [CrossRef]
- Garrett, K.A.; Mundt, C.C. Host diversity can reduce potato late blight severity for focal and general patterns of primary inoculum. Phytopathology 2000, 90, 1307–1312. [Google Scholar] [CrossRef] [PubMed]
- Wuest, S.E.; Peter, R.; Niklaus, P.A. Ecological and evolutionary approaches to improving crop variety mixtures. Nat. Ecol. Evol. 2021, 5, 1068–1077. [Google Scholar] [CrossRef] [PubMed]

Disclaimer/Publisher’s Note: The statements, opinions and data contained in all publications are solely those of the individual author(s) and contributor(s) and not of MDPI and/or the editor(s). MDPI and/or the editor(s) disclaim responsibility for any injury to people or property resulting from any ideas, methods, instructions or products referred to in the content. |
© 2023 by the authors. Licensee MDPI, Basel, Switzerland. This article is an open access article distributed under the terms and conditions of the Creative Commons Attribution (CC BY) license (https://creativecommons.org/licenses/by/4.0/).
Share and Cite
Uddin, M.J.; Huang, X.; Lu, X.; Li, S. Increased Conidia Production and Germination In Vitro Correlate with Virulence Enhancement in Fusarium oxysporum f. sp. cucumerinum. J. Fungi 2023, 9, 847. https://doi.org/10.3390/jof9080847
Uddin MJ, Huang X, Lu X, Li S. Increased Conidia Production and Germination In Vitro Correlate with Virulence Enhancement in Fusarium oxysporum f. sp. cucumerinum. Journal of Fungi. 2023; 9(8):847. https://doi.org/10.3390/jof9080847
Chicago/Turabian StyleUddin, Md. Jamal, Xiaoqing Huang, Xiaohong Lu, and Shidong Li. 2023. "Increased Conidia Production and Germination In Vitro Correlate with Virulence Enhancement in Fusarium oxysporum f. sp. cucumerinum" Journal of Fungi 9, no. 8: 847. https://doi.org/10.3390/jof9080847
APA StyleUddin, M. J., Huang, X., Lu, X., & Li, S. (2023). Increased Conidia Production and Germination In Vitro Correlate with Virulence Enhancement in Fusarium oxysporum f. sp. cucumerinum. Journal of Fungi, 9(8), 847. https://doi.org/10.3390/jof9080847

